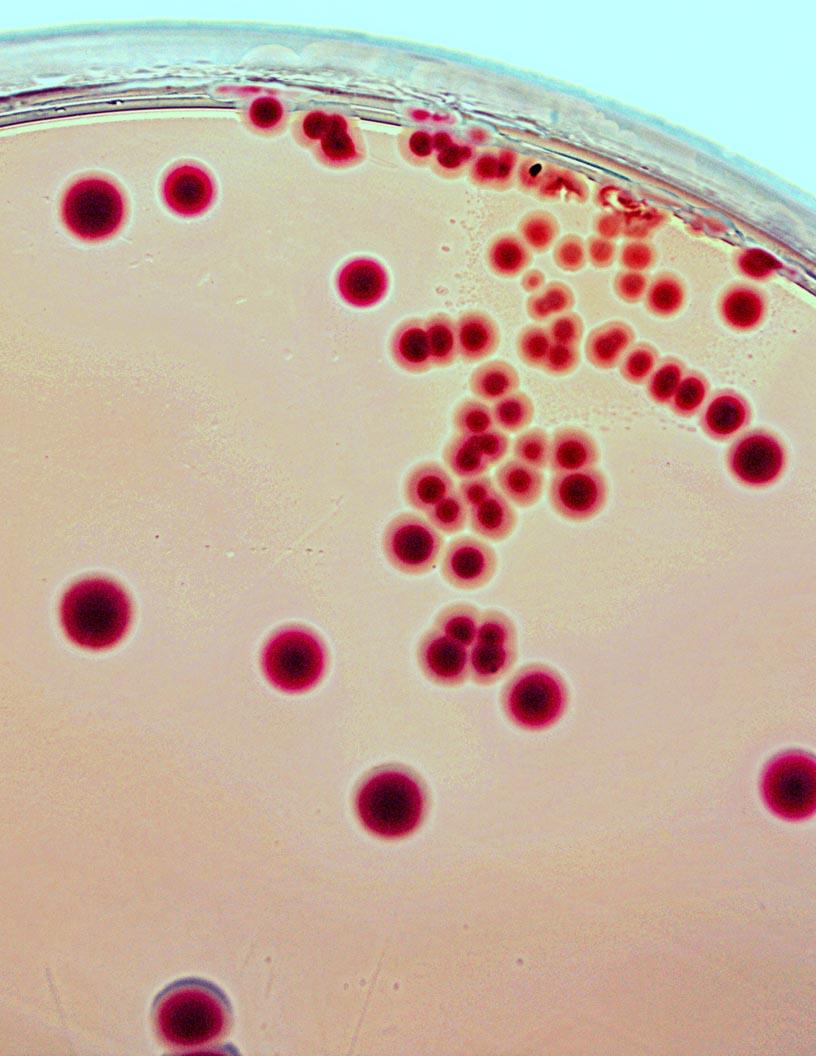
Escherichia Coli Testing Market Analysis, Size, and Forecast 2024-2028: North America (US and Canada), Europe (France, Germany, Italy, and UK), Middle East and Africa (UAE), APAC (China, India, Japan, and South Korea), and Rest of World (ROW)

Escherichia Coli Testing Market Size 2024-2028
The escherichia coli testing market size is forecast to increase by USD 756.2 million at a CAGR of 7.6% between 2023 and 2028.
- The Escherichia Coli (E. Coli) testing market is experiencing significant growth due to the rising incidence of waterborne diseases, which necessitates stringent monitoring and testing of water sources for E. Coli bacteria. Automation is another key driver in the market, with laboratories increasingly adopting automated methods for faster and more accurate E. Coli testing results. However, the healthcare market faces a notable challenge in the difficulty of culturing E. Coli, which can be notoriously difficult to isolate and grow in laboratories. This obstacle can lead to false negatives or delayed test results, potentially compromising public health. Companies in the E.
- Coli testing market must address this challenge through the development and implementation of advanced testing technologies and methods to ensure accurate and timely detection of E. Coli in various samples. By capitalizing on the market's growth drivers and effectively navigating the challenges, companies can position themselves for success in this essential industry.
What will be the Size of the Escherichia Coli Testing Market during the forecast period?
- The Escherichia coli (E. Coli) testing market continues to evolve, driven by the persistent need for ensuring food safety, regulatory compliance, and public health. This market spans various sectors, including food processing, clinical laboratories, healthcare facilities, water quality, and agricultural production. Bacterial contamination poses significant risks to these industries, necessitating continuous efforts to develop and adopt advanced testing methods. Traditional culture methods have long been the cornerstone of E. Coli detection, but the integration of machine learning, artificial intelligence, and big data is revolutionizing the landscape. Point-of-care testing, molecular diagnostics, and predictive analytics are gaining traction, enabling rapid detection and response to contamination incidents.
- Colony counting, antibiotic susceptibility testing, and sample preparation remain essential components of the testing process, underpinned by quality assurance and control practices. Consumer protection, regulatory compliance, and public awareness fuel market growth, with applications extending to pharmaceutical manufacturing and water treatment. The ongoing unfolding of market activities reveals a dynamic and evolving ecosystem, as stakeholders adapt to emerging trends and technologies.
How is this Escherichia Coli Testing Industry segmented?
The escherichia coli testing industry research report provides comprehensive data (region-wise segment analysis), with forecasts and estimates in "USD million" for the period 2024-2028, as well as historical data from 2018-2022 for the following segments.
- Type
- Environmental testing
- Clinical testing
- Distribution Channel
- Direct Sales
- Distributors
- Online Platforms
- End-User
- Hospitals
- Laboratories
- Food & Beverage Industry
- Test Type
- PCR-Based Tests
- Enzyme Immunoassays
- Culture-Based Tests
- Geography
- North America
- US
- Canada
- Europe
- France
- Germany
- Italy
- UK
- Middle East and Africa
- UAE
- APAC
- China
- India
- Japan
- South Korea
- Rest of World (ROW)
- North America
By Type Insights
The environmental testing segment is estimated to witness significant growth during the forecast period.
The market is witnessing significant growth due to the increasing concern for foodborne illnesses and the need for regulatory compliance in various industries. E. Coli bacteria can cause foodborne illnesses, leading to food recalls and supply chain disruptions. Clinical laboratories play a crucial role in diagnosing E. Coli infections in humans, while food processing facilities and water treatment plants employ testing to ensure food and water safety. Machine learning, artificial intelligence, and big data are revolutionizing E. Coli testing by enabling predictive analytics and rapid detection. Point-of-care testing is gaining popularity for its convenience and speed, while culture methods remain the gold standard for pathogen detection.
Colony counting and antibiotic susceptibility testing are essential components of microbiology testing, ensuring quality control and public health. Food processing and agricultural production face unique challenges in preventing bacterial contamination, requiring robust quality assurance measures. Pharmaceutical manufacturing also relies on E. Coli testing for ensuring product safety and molecular diagnostics for identifying specific strains. Water quality is another critical application area, with environmental monitoring and water treatment relying on E. Coli testing for ensuring safety. The environmental testing segment dominates the market due to its cost-effectiveness and applicability to various industries. Membrane filtration, multiple-tube fermentation, and enzyme-substrate methods are commonly used for E.coli.
Coli detection in environmental samples. Confirmation of presumptive positive results may require additional incubation time, highlighting the importance of accurate and efficient testing methods. Public awareness of foodborne illnesses and the need for consumer protection continue to drive the demand for E. Coli testing. As the market evolves, we can expect continued innovation in testing technologies and applications.
The Environmental testing segment was valued at USD 827.10 million in 2018 and showed a gradual increase during the forecast period.
Regional Analysis
North America is estimated to contribute 41% to the growth of the global market during the forecast period.Technavio's analysts have elaborately explained the regional trends and drivers that shape the market during the forecast period.
The North American market for Escherichia coli testing holds significance in the global landscape, marked by steady expansion driven by rigorous food safety regulations and advanced healthcare infrastructure. The United States leads this market due to its proactive public health policies and high consumer awareness of foodborne illnesses, necessitating stringent testing protocols. Technological advancements, such as polymerase chain reaction (PCR) and enzyme immunoassays, are transforming testing methodologies, enhancing detection accuracy and speed. The increasing prevalence of E. Coli-related infections underscores the importance of reliable testing solutions in both clinical and environmental contexts. In food processing, E. Coli testing is crucial for ensuring food safety and preventing potential outbreaks.
In healthcare facilities, it plays a vital role in diagnosing and treating patients with E. Coli infections. Machine learning, artificial intelligence, and big data are revolutionizing E. Coli testing by enabling predictive analytics, improving quality assurance, and streamlining sample preparation. The agricultural production and pharmaceutical manufacturing sectors also rely on E. Coli testing for microbiology and environmental monitoring, water treatment, and molecular diagnostics. Public awareness campaigns and regulatory compliance further fuel the market's growth, ensuring the highest standards of food safety, water quality, and consumer protection.
Market Dynamics
Our researchers analyzed the data with 2023 as the base year, along with the key drivers, trends, and challenges. A holistic analysis of drivers will help companies refine their marketing strategies to gain a competitive advantage.
The Escherichia coli (E. coli) Testing Market is advancing rapidly with cutting-edge technologies aimed at improving speed, accuracy, and scalability. Modern labs rely on PCR machines, ELISA readers, and automated incubators for reliable microbial analysis. Biosensors and biosensor innovations are enabling rapid E. coli detection with minimal sample preparation. Sequencing systems and culture plate readers offer detailed microbial profiling, while chromogenic scanners provide quick visual confirmation. Portable analyzers and portable PCR devices support field testing, critical for food safety and water monitoring. AI-powered diagnostics and automated testing platforms streamline operations in quality control labs, aided by multiplex testing and high-sensitivity assays. Backed by cloud servers and cloud-integrated systems, these solutions enable real-time monitoring and data access. The use of eco-friendly reagents ensures sustainability in modern testing workflows.
What are the key market drivers leading to the rise in the adoption of Escherichia Coli Testing Industry?
- Waterborne diseases, which are on the rise, serve as the primary market driver. According to the World Health Organization (WHO), waterborne diseases are a significant global health concern, causing over 3.4 million deaths annually. These diseases are particularly prevalent in developing and underdeveloped regions, with children being the most susceptible victims. Escherichia coli (E. Coli) testing plays a crucial role in ensuring the safety and quality of water for human consumption. This testing method identifies the presence of harmful organisms, elements, and compounds in water, enabling preventative measures to be taken. The importance of E.
- Coli testing is underscored by the potential health risks associated with contaminated water, which can lead to a range of illnesses, from mild gastrointestinal symptoms to life-threatening conditions.
What are the market trends shaping the Escherichia Coli Testing Industry?
- Escherichia coli testing is experiencing a significant trend towards automation. This upward trajectory in automation represents a notable development within the industry.
- Escherichia Coli (E. Coli) testing is a crucial aspect of supply chain management and regulatory compliance in various industries, including food processing and healthcare facilities. Foodborne illness caused by bacterial contamination, such as E. Coli O157:H7, poses significant risks to public health and can lead to costly recalls and damage to brand reputation. Immunomagnetic separation (IMS) is an advanced method for detecting E. Coli in large food and water samples. This technique utilizes magnetic beads coated with antibodies specific to the target bacteria, enabling selective separation and concentration. Real-time polymerase chain reaction (PCR) is then employed for high-sensitivity detection, ensuring accurate results within a three-hour process.
- This approach, which can handle sample volumes up to 250 ml, is particularly valuable for industries dealing with large quantities of food products like milk, ground beef, and cabbage. By detecting E. Coli in the range of 101â102 colony-forming units per milligram (mg) or gram (g) of sample, food processors and healthcare facilities can effectively mitigate risks associated with bacterial contamination and maintain regulatory compliance. In conclusion, the use of IMS and real-time PCR for E. Coli testing offers a rapid, sensitive, and selective solution for ensuring food and water safety, ultimately contributing to improved supply chain management and public health.
What challenges does the Escherichia Coli Testing Industry face during its growth?
- The inability to effectively culture methods poses a significant challenge to the industry's growth. This issue, which requires the attention of professionals and experts, hinders advancements and expansion in the field.
- E. Coli testing is a critical aspect of food and water safety, ensuring consumer protection against potential infections. Traditional methods for identifying E. Coli and other microorganisms include microscopy, culture, phenotypic and genotypic methods, and nucleic acid amplification. Culture-based profiling, the most common approach, can be time-consuming and ineffective for certain organisms that are unculturable or non-culturable against standard culture media. Advancements in technology have led to the emergence of alternative methods, such as matrix-assisted laser desorption ionization-time of flight (MALDI-TOF) and polymerase chain reaction (PCR), which can detect the expression of thousands of genes simultaneously. These methods have increased the accuracy and efficiency of E.
- Coli testing. Moreover, recent advancements in machine learning, artificial intelligence, and big data have the potential to revolutionize E. Coli testing. These technologies can analyze vast amounts of data to identify patterns and trends, enabling early detection and rapid response to potential outbreaks. Antibiotic susceptibility testing is another crucial aspect of E. Coli testing, ensuring the appropriate use of antibiotics and reducing the risk of antibiotic resistance. Point-of-care testing is gaining popularity due to its convenience and speed, allowing for quick results and timely intervention. In conclusion, the E. Coli testing market is driven by the need for accurate, efficient, and rapid testing methods to ensure food and water safety and protect consumer health. The integration of advanced technologies such as machine learning, artificial intelligence, and big data is expected to further enhance the capabilities of E. Coli testing and improve overall public health.
Exclusive Customer Landscape
The escherichia coli testing market forecasting report includes the adoption lifecycle of the market, covering from the innovator's stage to the laggard's stage. It focuses on adoption rates in different regions based on penetration. Furthermore, the escherichia coli testing market report also includes key purchase criteria and drivers of price sensitivity to help companies evaluate and develop their market growth analysis strategies.
Customer Landscape
Key Companies & Market Insights
Companies are implementing various strategies, such as strategic alliances, escherichia coli testing market forecast, partnerships, mergers and acquisitions, geographical expansion, and product/service launches, to enhance their presence in the industry.
Abbott Laboratories - The company specializes in advanced microbiological testing for Escherichia coli, employing ELISA, PCR, and MALDI Tof techniques. These procedures ensure accurate and efficient detection and identification of E. Coli strains. ELISA (Enzyme-Linked Immunosorbent Assay) offers high sensitivity and specificity, making it ideal for detecting E. Coli in various samples.
The industry research and growth report includes detailed analyses of the competitive landscape of the market and information about key companies, including:
- Abbott Laboratories
- Beckman Coulter
- Bio-Rad Laboratories
- bioMérieux SA
- Charles River Laboratories
- Danaher Corporation
- Eiken Chemical
- Enzo Life Sciences
- Hygiena Corporation
- IDEXX Laboratories
- Merck KGaA
- Neogen Corporation
- PerkinElmer
- QIAGEN
- Roche Diagnostics
- Romera Group
- Sysmex Corporation
- Thermo Fisher Scientific
- Trinity Biotech
- Wako Chemicals
Qualitative and quantitative analysis of companies has been conducted to help clients understand the wider business environment as well as the strengths and weaknesses of key industry players. Data is qualitatively analyzed to categorize companies as pure play, category-focused, industry-focused, and diversified; it is quantitatively analyzed to categorize companies as dominant, leading, strong, tentative, and weak.
Recent Development and News in Escherichia Coli Testing Market
- In February 2024, Thermo Fisher Scientific, a leading life sciences solutions provider, introduced the GeneScan System for E. Coli Detection, gaining significant attention due to its ability to provide rapid and accurate results in just a few hours (Thermo Fisher Scientific Press Release, 2024). This innovation marked a significant technological advancement in the market, enhancing the efficiency and reliability of E. Coli diagnostics.
- In October 2025, Merck KGaA, a renowned pharmaceutical and life science company, announced a strategic partnership with Bio-Rad Laboratories, a leading provider of life science research and clinical diagnostic products, to expand their offerings in the food safety testing segment, including E. Coli testing (Merck KGaA Press Release, 2025). This collaboration aimed to combine their expertise and resources, creating a stronger market presence and enhancing their ability to cater to the growing demand for food safety testing.
- In March 2024, Quidel Corporation, a leading provider of rapid diagnostic testing solutions, received FDA approval for its Solana® System and Lyra® Direct E. Coli Assay, expanding its product offerings and strengthening its position in the market (Quidel Corporation Press Release, 2024). This approval marked a key regulatory milestone, enabling Quidel to cater to the increasing demand for rapid and accurate E. Coli testing solutions in various industries, including food and water testing.
- In May 2025, 3M, a global science-based technology company, invested USD100 million in its Microbiology business to expand its capacity for rapid diagnostic testing, including E. Coli testing (3M Press Release, 2025). This substantial investment signaled a significant commitment to the market and demonstrated 3M's confidence in the growing demand for rapid and reliable testing solutions. This expansion was expected to increase 3M's production capacity and enhance its ability to meet the evolving needs of its customers.
Research Analyst Overview
The Escheschia coli testing market is driven by the persistent threat of foodborne disease outbreaks caused by various pathogenic strains, including uropathogenic and enterotoxigenic E. Coli. Shelf life and epidemiological surveillance are critical factors in food safety, necessitating the use of advanced testing technologies such as lateral flow assays, real-time PCR, and next-generation sequencing. Fecal contamination is a significant concern, leading to the development of microfluidic devices for rapid and accurate detection of coliform bacteria and pathogenic strains like O157:h7, enterohemorrhagic, and enterotoxigenic E. Coli. Quality management systems and microbial risk management play essential roles in outbreak investigations, while food safety education increases consumer awareness and demand for effective testing solutions.
Market is evolving with highly specialized solutions tailored to food, water, and health safety. PCR testing kits for food safety are essential in detecting contamination across supply chains. For environmental needs, rapid E. coli tests for water quality and portable testing devices for environmental monitoring offer quick, on-site results. AI-powered diagnostics for clinical labs and automated systems for dairy testing enhance efficiency and accuracy. In meat and beverage industries, molecular assays for meat processing and real-time PCR for beverage safety ensure compliance and product integrity. Biosensor technology for public health supports early outbreak detection, while chromogenic media for veterinary diagnostics aids in animal health monitoring. Cloud-based reporting for E. coli testing enables seamless data sharing and real-time tracking across global safety networks.
Antimicrobial resistance poses a challenge, necessitating continuous innovation in testing technologies and food safety standards. Public health interventions and whole genome sequencing are crucial tools in understanding and mitigating the risks associated with foodborne diseases caused by E. Coli.
Dive into Technavio's robust research methodology, blending expert interviews, extensive data synthesis, and validated models for unparalleled Escherichia Coli Testing Market insights. See full methodology.
|
Market Scope |
|
|
Report Coverage |
Details |
|
Page number |
164 |
|
Base year |
2023 |
|
Historic period |
2018-2022 |
|
Forecast period |
2024-2028 |
|
Growth momentum & CAGR |
Accelerate at a CAGR of 7.6% |
|
Market growth 2024-2028 |
USD 756.2 million |
|
Market structure |
Fragmented |
|
YoY growth 2023-2024(%) |
6.9 |
|
Key countries |
US, Canada, Germany, China, UK, Japan, India, France, Italy, South Korea, Rest of World (ROW), and UAE |
|
Competitive landscape |
Leading Companies, Market Positioning of Companies, Competitive Strategies, and Industry Risks |
What are the Key Data Covered in this Escherichia Coli Testing Market Research and Growth Report?
- CAGR of the Escherichia Coli Testing industry during the forecast period
- Detailed information on factors that will drive the growth and forecasting between 2024 and 2028
- Precise estimation of the size of the market and its contribution of the industry in focus to the parent market
- Accurate predictions about upcoming growth and trends and changes in consumer behaviour
- Growth of the market across North America, Europe, Asia, and Rest of World (ROW)
- Thorough analysis of the market's competitive landscape and detailed information about companies
- Comprehensive analysis of factors that will challenge the escherichia coli testing market growth of industry companies
We can help! Our analysts can customize this escherichia coli testing market research report to meet your requirements.

RIA -
RIA - 
